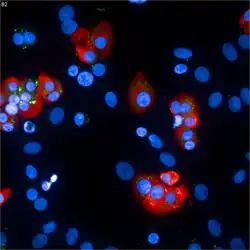

Phénotype économe
L'hypothèse du phénotype économe ou phénotype d'épargne[1],[2],[3] ou parfois hypothèse de Barker (Barker's hypothesis), indique qu'une croissance fœtale réduite est fortement associée à un certain nombre d'états ou de maladies chroniques durant la vie. Cette susceptibilité accrue résulte des adaptations faites par le fœtus dans un environnement limité dans son apport en nutriments. Le phénotype économe est une composante de l'hypothèse de la programmation fœtale (en). Les maladies et états chroniques liées à un phénotype économe incluent les maladies coronarienne, les accidents vasculaires cérébraux, le diabète et l'hypertension.
Définition et caractéristiques
« L'hypothèse du phénotype économe suggère que les adaptations métaboliques précoces aident à la survie de l'organisme en sélectionnant une trajectoire de croissance appropriée en réponse aux signaux environnementaux »[4]. Le concept du phénotype économe est l'une des composantes de l'hypothèse de la programmation fœtale (en)[5],[6]. Les maladies et états chroniques associés à un phénotype économe comprennent les maladies coronariennes, les accidents vasculaires cérébraux, le diabète et l'hypertension[7]. Un phénotype économe peut également entraîner des troubles auditifs[8].
Cette théorie est parfois appelée l'hypothèse de Barker, d'après le nom du professeur David James Purslove Barker (1938-2013), chercheur à l'université de Southampton et qui a publié ce concept en 1990[9],[10],[11],[12].
Historique
Premiers concepts et recherches
Le modèle proposé par Barker n'est le premier concept ayant été suggéré pour expliquer la relation entre une anomalie de la croissance et la taille fœtales et les risques de troubles pathologiques ultérieurs[13]. Dans les années 1950, l'épidiomologiste Jørgen Pedersen (en) propose une thèse selon laquelle une surexposition précoce au glucose dans le milieu intra-utérin conduirait à une organomégalie ainsi qu'à un développement prénatal excessif prédisposant ainsi le fœtus à des symptômes diabétiques[14]. En 1960, Priscilla White effectue des observations déterminantes sur la forte prévalence de la tolérance anormale au glucose chez les enfants conçus par des femmes présentant un diabète[13],[15]. Un modèle de « génotype économe » a été proposé par le généticien américain James V. Neel en 1962[16],[17],[18],[13]. Le modèle de Neel indique que le génotype économe permet « à l'organisme de préserver ses réserves énergétiques pour lutter contre les périodes de famine et de restriction alimentaire »[19], expliquant ainsi que les populations de chasseurs-cueilleurs porteurs de ce gène auraient mieux résisté aux périodes de famine en stockant pendant les périodes d'abondance des réserves de graisse dans les tissus adipeux[20]. Les recherches de Neel ont principalement été observées sur des personnes appartenant au peuple des Pimas. Les études de Neel ont été ultérieurement portées sur des populations micronésiennes et polynésiennes présentant un diabète de type 2[21]. Ultérieurement, Pettitt met en évidence que la fréquence de l'obésité et du diabète de type II est plus importante chez les enfants dont les mères ont été atteintes du diabète durant leur grossesse[21]. En 1972, Brook, en se basant sur la phase de différenciation des adipocytes survient en grande partie in utero, suggère que les influences affectant le fœtus durant cette étape pourraient le prédisposer à une obésité postérieure[21]. Au début des années 1980, R. K. Freinkel, étend le concept de Neel en proposant l'implication de métabolites intermédiaires[21],[22]. Ultérieurement, David J. Pettitt et ses collaborateurs proposent une corrélation entre l'obésité et le diabète de type II observés chez des enfants et le diabète affectant leurs mères durant leurs grossesses[21],[23].
Protocole et recherches sur le phénotype économe
Une trentaine d'années après l'hypothèse suggérée par Neel, le modèle publié par Barker en 1990 généralise ce concept[21]. Au début des années 1990, Barker, associé à C. Nicholas Hales, se sont intéressés aux relations existant entre les conditions de vie de groupes socio-économiques pauvres du Royaume-Uni et la fréquence de maladies chroniques observées au sein de ces populations[21]. L'hypothèse de Barker a été établie d'après des recherches et études réalisées sur une période d'un an et portant sur une cohorte de 428 hommes originaires du comté du Hertfordshire (Angleterre de l'Est) et affectés d'une intolérance au glucose ou d'un diabète de type 2[24],[21]. Ultérieurement, d'autres recherches ont été menées sur des cohortes présentant les mêmes pathologies. L'une de ces recherches a été réalisée sur une population d'hommes et de femmes nés durant l'hiver de la faim de 1944-1945 aux Pays-Bas. Les femmes ayant conçu ces personnes étaient, lors de cet événement, en état de sous-alimentation : leurs rations alimentaires quotidienne, au cours de leurs grossesses, étaient de l'ordre de 400 à 800 kilocalories[19],[21]. Les tests de tolérance orale au glucose (TTOG) effectués sur cette population ont mis en évidence, passé un délai de deux heures, une forte concentration glycémique chez chacune de ces personnes, en particulier celles dont les mères avaient été touchées par la famine de 1944-1945 au cours de leurs trois derniers mois de grossesse[Note 1],[25]. Les recherches de Barker et Hales ont indiqué qu'un environnement intra-utérin pauvre en nutriments pourrait affecter la croissance d'organes vitaux — notamment celle du cerveau — et pourrait également conduire à une hypoplasie du pancréas endocrine résultant d'un déficit en cellules bêta pancréatiques[24],[Note 2]. Le modèle du phénotype économe indique également un lien entre un faible poids du nouveau-né et l'apparition d'un diabète de type II[19]. Ces études ont montré que les adaptations consécutives en un milieu intra-utérin pauvre en nutriments entraînent un accroissement des chances de survie d'un fœtus par le biais d'un « développement parcimonieux du cerveau (en) »[24].
Postériorité du concept de Barker
En 2007, Jonathan Wells inventorie et examine plusieurs concepts évolutifs, complémentaires ou concurrents, au modèle du phénotype économe de Barker[26]. Puis, en 2008, R. Stöger propose l'hypothèse d'un épigénotype économe, un concept s'appuyant sur des arguments opposés au modèle de Neel[27],[26],[Note 3]. Bien qu'il ait été fortement controversé, le concept proposé par Barker est actuellement utilisé par de nombreux pédiatres afin de prévenir et diagnostiquer les troubles pathologiques fréquents (diabète, hypertension, maladies coronariennes) survenant à l'âge adulte[10],[21].
Effets favorables
Avantages pour le fœtus
Les partisans ou tenants de cette hypothèse suggèrent que dans les conditions nutritionnelles pauvres — ces déficits en apports nutritionnels impactent notamment des unités fonctionnelles et structurelles telles que les cellules pancréatiques de type β ; les néphrons et cardiomyocytes —, une femme enceinte peut modifier le développement de son enfant à naître de sorte qu'il sera préparé pour la survie dans un environnement dans lequel les ressources sont susceptibles d'être limitées, résultant en un phénotype économe[29],[30].
Récemment, certains scientifiques ont proposé que le phénotype économe pourrait probablement préparer l'organisme pour son environnement adulte à long terme[31],[32],[33],[24].
Avantages pour la mère

Cependant, les changements environnementaux au début du développement peuvent faire en sorte que la trajectoire choisie devienne inappropriée, entraînant des effets néfastes sur la santé. Ce paradoxe génère des doutes quant à savoir si le phénotype économe est adaptatif pour la progéniture humaine. Ainsi, le phénotype économe doit être considéré comme la capacité de toute la progéniture à répondre aux signaux environnementaux au cours du développement ontogénétique précoce. Il a été suggéré que le phénotype économe est la conséquence de trois processus adaptatifs différents : les effets maternels, la construction de niche de cellules souches et la plasticité développementale (en), ces trois processus étant tous influencés par le cerveau, via la glande endocrine[31],[13]. Tandis que la plasticité développementale démontre une adaptation par la progéniture, la construction de niche et les effets maternels sont le résultat des sélections parentales plutôt que de la forme physique de la progéniture. Par conséquent, le phénotype économe peut être décrit comme une manipulation du phénotype de la progéniture pour le bénéfice de la condition physique maternelle. L'information qui entre dans le phénotype de la progéniture au début du développement reflète l'expérience développementale de la mère et la qualité de l'environnement au cours de sa propre maturation plutôt que de prédire le futur possible de l'environnement du nourrisson[31],[13].
Effets défavorables
De nombreuses maladies humaines apparaissant à l'âge adulte sont liées aux modes de croissance du début de la vie, ce qui détermine la nutrition prénatale comme mécanisme sous-jacent. Les individus ayant un phénotype économe auront, selon John Waterlow en 1990[34], puis Bateson et Martin en 1999 : « une taille corporelle plus petite, un taux métabolique réduit et un niveau réduit d'activité comportementale [...] des adaptations à un environnement qui manque chroniquement de nourriture » (« a smaller body size, a lowered metabolic rate and a reduced level of behavioural activity [...] adaptations to an environment that is chronically short of food »)[7],[35],[36]. Les individus ayant un phénotype économe et qui se développent dans un milieu intra-utérin riche en apports nutritionnels peuvent être plus sujets à des troubles métaboliques tels que l'obésité et le diabète de type 2[33],[24], alors que ceux qui ont reçu une prévision (programmation) maternelle positive seront adaptés à de bonnes conditions et à des régimes riches[37]. Cette théorie, proposée et publiée par David Barker en 1991[38] est actuellement maintenant largement acceptée et constitue une source de préoccupation pour les sociétés de pays en développement marquées par la transition d'une malnutrition et d'une sous-alimentation vers de meilleures nutritions et alimentation[39],[1],[13].
Les facteurs de risque d'apparition et de développement d'un phénotype économe comprennent l'âge maternel avancé (en)[40],[37] et l'insuffisance utéroplacentaire (en)[41].
Mécanismes moléculaires et développementaux

La capacité ou l'aptitude de conserver, d'acquérir et de dépenser de l'énergie semble indiquer un ancien trait inné qui est intégré dans le génome d'une manière qui conduit à protéger contre les mutations[42],[43]. Il est également possible que ces changements peuvent être hérités d'une génération à l'autre[43],[42],[44],[45],[46]. Ce mécanisme génétique héréditaire peut être appréhendé sous les termes de « diabète de type adulte chez le jeune » (MODY)[21],[47]. Le gène codant la leptine[Note 4] (hormone de la satiété) a été identifié comme étant possiblement l'unité génétique responsable dans l'acquisition de ces traits économes[42],[44],[43].
Sur une plus grande échelle anatomique, les mécanismes moléculaires sont largement causés par un environnement sous-optimal dans l'appareil reproducteur[33],[49] ou par des adaptations physiologiques maternelles (en) durant la grossesse[31],[50],[51],[45].
D'autre part, pour préciser le mécanisme du phénotype économe, il est possible de l'expliquer par l'existence de certaines « fenêtres de développement clés » durant lesquelles les expositions « fixent » des systèmes physiologiques et peuvent ainsi entraîner à des états ou maladies chroniques apparaissant à long terme[21],[48]. Ce modèle a été désigné sous les termes de « programmation environnementale »[21].
Notes et références
Notes
- ↑ Ces caractéristiques, également identifiées sur d'autres cohortes ayant été soumises aux mêmes conditions lors de leur développement fœtal, ont montré qu'une intolérance au glucose était associée à un faible poids à la naissance et à d'importants risques d'obésité à l'âge adulte indiquant ainsi une possible corrélation entre des facteurs prénatals et des facteurs postnatals. En outre, ces observations ont mis en évidence qu'une faible croissance fœtale est induite par un apport nutritionnel restreint en milieu intra-utérin[25].
- ↑ L'un des arguments exposés par Barker étant qu'en phase de croissance fœtale, pour faire face à des conditions de restrictions nutritionnelles, la distribution énergétique se réalise en faveur du pancréas et au détriment d'autres tissus tels que ceux du cerveau[26].
- ↑ Pour Robert W. O’Rourke, le modèle de Neel s'appui en grande partie sur des arguments évolutionnistes[28].
- ↑ La leptine, qui détermine l’équilibre énergétique d'un organisme via la régulation électrophysiologique des neurones agissant sur la prise alimentaire — d'une part celles à protéines neuropeptidique Y/peptide Agouti (AgRP) (en), unités exprimées par le noyau arqué, et d'autre part celles à protéines proopiomélanocortine/neuropeptidique CART (en) et αMSH —, joue un rôle important sur une partie des neurones de l'hypothalamus intervenant dans les mécanismes de satiété. La leptine intervient également dans le mécanisme de plasticité de ces neurones. Néanmoins, l'impact de la leptine sur ce groupe de neurones n'est déterminant que pendant une courte phase post-natale[48].
Références
- 1 2 Maryse Hamelin Raynaud, « Les origines de l’épidémie de diabète et de maladies cardiovasculaires », publications du Pôle DFN, , page 15 (lire en ligne [PDF], consulté le ).
- ↑ Catherine Bernard, Odile Della Zuana et Alain Ktorza, « Interaction entre facteurs d’environnement et fonds génétique dans le diabète de type 2 : L’apport des modèles animaux - Interaction between environment and genetic background in type 2 diabetes: lessons from animal models », Med Sci (Paris), vol. 29, nos 8-9, , page 793 (Sous-nutrition fœtale et néonatale - Les données chez l’homme) (lire en ligne, consulté le ).
- ↑ C. Julien, « Obésité-diabète : génotype et/ou phénotype dʼépargne ? », Cholé-doc, no 69, (lire en ligne, consulté le ).
- ↑ (en) S. Ulisaszejk et E. Bryant, « Binge Eating, Dishinbition and Obesity », dans Alexandra Alvergne, Crispin Jenkinson et Charlotte Faurie (directeurs de publication), Evolutionary Thinking in Médicine : From Research to Policy and Practice, Springer, , 382 p. (lire en ligne), page 114.
- ↑ Hélène Delisle, « La programmation fœtale des maladies chroniques liées à la nutrition », Cahiers d'études et de recherches francophones / Santé, vol. 12, no 1, (lire en ligne).
- ↑ Marie-Aline Charles, Cyrille Delpierre et Bernadette Bréant, « Le concept des origines développementales de la santé : Évolution sur trois décennies - Developmental origin of health and adult diseases (DOHaD): evolution of a concept over three decades », Med Sci (Paris), vol. 32, no 1 (dossier Origine développementale de la santé et des maladies (DOHaD), environnement et épigénétique), (lire en ligne, consulté le ).
- 1 2 (en) Peter LaFrenière, « Infancy and Childhood », dans Peter LaFrenière, Adaptive Origins : Evolution and Human Development, Psychology Press, , 408 p. (lire en ligne), pages 170 à 185.
- ↑ (en) Marie-Louise Barrenäs, Åsa Bratthall et Jovanna Dahlgren, « The thrifty phenotype hypothesis and hearing problems », The British Medical Journal, no 327, (DOI 10.1136/bmj.327.7425.1199, lire en ligne, consulté le ).
- ↑ (en) « Barker hypothesis », sur le site de l'Oxford University Press (consulté le ).
- 1 2 (en) Georges J. Dover, « How Pediatricans Will Diagnose and Prevent Common Adult-Onset Diseases », Transactions of the American Clinical and Climatological Association, vol. 120, , p. 199–207 (lire en ligne, consulté le ).
- ↑ (en) John Ely, Tony Zavaskis et Susan Wilson, « Diabetes and stress : an anthropological review for study of modernizing populations in the US-Mexico border region », Rural and Remote Health, vol. 11, no 1758, (lire en ligne, consulté le ).
- ↑ (en) David J. Baker, « Maternal nutrition, fetal nutrition, and disease in later life. », Nutrition, vol. 13, no 9, , page 807 (DOI 10.1016/S0899-9007(97)00193-7).
- 1 2 3 4 5 6 (en) Jonathan C. K. Wells, « Environmental Quality, Developmental Plasticity and the Thrifty Phenotype : A Review of Evolutionary Models », Evolutionary Bioinformatics, SAGE Publications, vol. 3, (DOI 10.1177/117693430700300027, lire en ligne, consulté le ).
- ↑ (en) Jørgen Pedersen, « Weight and length at birth of infants of diabetic mothers », Acta endocrinologica, vol. 16, , p. 330 à 342 (lire en ligne, consulté le ).
- ↑ (en) Pricillia White, « Childhood Diabètes : Its Course, and Influence on the Second and Third Generations: The Banting Memorial Lecture 1960 », Diabetes, vol. 9, no 5, , p. 345-355 (DOI 10.2337/diab.9.5.345, lire en ligne, consulté le ).
- ↑ (en) « Thrifty gene hypothesis », sur le site ScienceDirect, Elsevier (consulté le ).
- ↑ (en) James V. Neel, « Diabetes mellitus : a "thrifty" genotype rendered detrimental by "progress"? », American Journal of Human Genetics, vol. 14, , p. 353-62 (PMID 13937884, PMCID PMC1932342, présentation en ligne).
- ↑ (en) A. M Sharma, « The thrifty-genotype hypothesis and its implications for the study of complex genetic disorders in man. », Journal of Molecular Medicine (Berlin), vol. 76, no 8, , p. 568-71 (lire en ligne, consulté le ).
- 1 2 3 Odile Couvreur, « 1. Le concept de programmation : 1.2.1. L’hypothèse du phénotype économe », dans Odile Couvreur, Le contrôle hypothalamique de l’homéostasie énergétique : impact de l’environnement maternel et implication du CNTF., Université Paris-Sud - Paris XI, , 260 p. (lire en ligne [PDF]), pages 58 à 60.
- ↑ (en) Jack James, The Health of Populations: Beyond Medicine, Academic Press, (lire en ligne), p. 36
- 1 2 3 4 5 6 7 8 9 10 11 12 13 (en) Robert S. Lindsay et Peter H. Bennett, « Type 2 diabetes, the thrifty phenotype – an overview », British medical bulletin, vol. 60, no 1, , p. 21–32 (DOI 10.1093/bmb/60.1.21, lire en ligne, consulté le ).
- ↑ (en) « Banting Lecture 1980 : of Pregnancy and Progeny », Diabetes, vol. 29, no 12, , p. 1023-1035 (DOI 10.2337/diab.29.12.1023, lire en ligne, consulté le ).
- ↑ (en) David J. Pettitt, H. Robert Baird, Kirk A. Aleck et al., « Excessive Obesity in Offspring of Pima Indian Women with Diabetes during Pregnancy », The New England Journal of Medicine, vol. 308, , p. 242-245 (DOI 10.1056/NEJM198302033080502, lire en ligne, consulté le ).
- 1 2 3 4 5 (en) Bonnie Brenseke, M. Renee Prater, Javiera Bahamonde et J. Claudio Gutierrez, « Current Thoughts on Maternal Nutrition and Fetal Programming of the Metabolic Syndrome », Journal of Pregnancy, , p. 1-13 (DOI 10.1155/2013/368461, lire en ligne, consulté le ).
- 1 2 (en) S. C. Langley-Evans (dir.), « Growth and Non-insuline dependant diabètes », dans S. C. Langley-Evans et al., Fetal Nutrition and Adult Disease : Programming of Chronic Disease Through Fetal Exposure to Undernutrition, CAB International, , 433 p. (lire en ligne), pages 160 à 168.
- 1 2 3 (en) Elizabeth A. Genné-Bacon, « Thinking Evolutionarily About Obesity », Yale Journal of Biology and Médicine, Yale University Press, vol. 87, no 2, , p. 99–112 (lire en ligne, consulté le ).
- ↑ (en) R. Stöger, « The thrifty epigenotype : an acquired and heritable predisposition for obesity and diabetes? », BioEssays, vol. 30, no 2, , p. 156–66 (PMID 18197594, DOI 10.1002/bies.20700).
- ↑ (en) Robert W. O’Rourke, « Metabolic thrift and the genetic basis of human obesity », Annals of Surgery, Lippincott Williams & Wilkins, vol. 259, no 4, , p. 642–648 (DOI 10.1097/SLA.0000000000000361, lire en ligne, consulté le ).
- ↑ (en) C.N Hales et David James Purslove Barker, « Type 2 (non-insulin-dependent) diabetes mellitus : the thrifty phenotype hypothesis », Diabetologia, vol. 35, no 7, , p. 595–601 (PMID 1644236, DOI 10.1007/BF00400248).
- ↑ C. Nicholas Hales et David James Purslove Barker, « The thrifty phenotype hypothesis : Type 2 diabetes », British medical bulletin, vol. 60, no 1, , p. 5–20 (PMID 11809615, DOI 10.1093/bmb/60.1.5, lire en ligne, consulté le ).
- 1 2 3 4 (en) J. C. Wells, « The thrifty phenotype as an adaptive maternal effect. », Biological Reviews Cambridge Philosophical Society, Cambridge Philosophical Society, vol. 82, no 1, , p. 143-72 (lire en ligne, consulté le ).
- ↑ (en) Ian J. Rickard, « Binge Eating, Dishinbition and Obesity », dans Alexandra Alvergne, Crispin Jenkinson et Charlotte Faurie (directeurs de publication), Evolutionary Thinking in Médicine : From Research to Policy and Practice, Springer, , 382 p. (lire en ligne), page 114.
- 1 2 3 (en) Jonathan C. K. Wells, « The Thrifty Phenotype Hypothesis : Thrifty Offspring or Thrifty Mother? », Journal of Theoretical Biology, Elsevier, vol. 221, no 1, , p. 143-161 (lire en ligne, consulté le ).
- ↑ (en) Susan Oyama, Paul E. Griffiths et Russell D. Gray, « Behavorial Development and Darwinian Evolution », dans Susan Oyama, Paul E. Griffiths et Russell D. Gray, Cycles of Contingency : Developmental Systems and Evolution, MIT Press, , 377 p. (lire en ligne).
- ↑ (en) Patrick Bateson, Behaviour, Development and Evolution, Open Book Publishers, , 134 p. (lire en ligne), page 91.
- ↑ (en) Patrick Bateson, Paul Patrick Gordon Bateson et Paul Martin, « Alternative Lifes », dans Patrick Bateson, Paul Patrick Gordon Bateson et Paul Martin, Design for a Life : How Biology and Psychology Shape Human Behavior, Simon and Schuster, , 271 p. (lire en ligne).
- 1 2 (en) R Huw Jones et Susan E Ozanne, « Fetal Programming of Glucose-Insulin Metabolism. », Molecular and Cellular Endocrinology, Elsevier, vol. 297, nos 1-2, (DOI 10.1016/j.mce.2008.06.020, lire en ligne [PDF], consulté le ).
- ↑ (en) David Baker, « Fetal and Infant origins on Adult diseases », British Medical Journal, Londres, vol. 302, no 12, , p. 113 (lire en ligne [PDF], consulté le ).
- ↑ (en) R. Robinson, « The fetal origins of adult disease : No longer just a hypothesis and may be critically important in south Asia », British Medical Journal, vol. 322, no 7283, , p. 375–6 (PMID 11179140, PMCID 1119617, DOI 10.1136/bmj.322.7283.375, lire en ligne, consulté le ).
- ↑ (en) R. W. Redline, « Endocrine Placenta », dans Ricardo V. Lloyd et al., Endocrine Pathology : Differential Diagnosis and Molecular Advances, Springer Science & Business Media, , 607 p. (lire en ligne), pages 464 à 467.
- ↑ (en) Kara Calkins et Sherin U. Devaskar, « Fetal Origins of Adult Disease », Current Problems in Pediatric and Adolescent Health Care, Elsevier, vol. 41, no 6, , p. 158–176 (DOI 10.1016/j.cppeds.2011.01.001, lire en ligne, consulté le ).
- 1 2 3 (en) R. Chamorro-Garcia, C. Diaz-Castillo, B. M. Shoucri et al., « Ancestral perinatal obesogen exposure results in a transgenerational thrifty phenotype in mice. », Nature Communications, vol. 8, no 1, (DOI 10.1038/s41467-017-01944-z., lire en ligne, consulté le ).
- 1 2 3 R. Stöger, « The thrifty epigenotype : an acquired and heritable predisposition for obesity and diabetes? », BioEssays, vol. 30, no 2, , p. 156–66 (PMID 18197594, DOI 10.1002/bies.20700).
- 1 2 (en) Chittaranjan S Yajnik, « Commentary : Thrifty phenotype: 20 years later », International Journal of Epidemiology, vol. 42, no 5, , p. 1227–1229 (DOI 10.1093/ije/dyt132, lire en ligne, consulté le ).
- 1 2 (en) C. E. Aiken et S. E. Ozanne, « Transgenerational developmental programming », Human Reproduction Update, vol. 20, , p. 63 (DOI 10.1093/humupd/dmt043, lire en ligne, consulté le )
- ↑ (en) Bruno Sauce, Carolina P. Goes, Isabela Forti et al., « A link between thrifty phenotype and maternal care across two generations of intercrossed mice », PLOS ONE, (lire en ligne, consulté le ).
- ↑ « Le diabète de type MODY », sur le site ajd-diabète.fr (consulté le ).
- 1 2 Claudine Junien, Catherine Gallou-Kabani, Alexandre Vige et Marie-Sylvie Gross, « Épigénomique nutritionnelle du syndrome métabolique », Med Sci (Paris), Inserm, vol. 21, no 4, , p. 396–404 (DOI 10.1051/medsci/2005214396, lire en ligne, consulté le ).
- ↑ (en) A. A. Vaag, L. G. Grunnet, G. P. Arora et al., « The thrifty phenotype hypothesis revisited », Diabetologia, vol. 55, no 8, , p. 2085–2088 (DOI 10.1007/s00125-012-2589-y, lire en ligne, consulté le ).
- ↑ (en) Caitlin J Smith et Kelli K Ryckman, « Epigenetic and developmental influences on the risk of obesity, diabetes, and metabolic syndrome », Diabetes, Metabolic Syndrome and Obesity: Targets and Therapy, no 8, , p. 295–302 (DOI 10.2147/DMSO.S61296, lire en ligne, consulté le ).
- ↑ (en) Simon C. Langley-Evans, « Developmental programming of health and disease », Proc Nutr Soc., vol. 65, no 1, , p. 97–105 (lire en ligne, consulté le ).
Pour approfondir
Bibliographie
: document utilisé comme source pour la rédaction de cet article.
- (en) Robert S. Lindsay et Peter H. Bennett, « Type 2 diabetes, the thrifty phenotype – an overview », British medical bulletin, vol. 60, no 1, , p. 21–32 (DOI 10.1093/bmb/60.1.21, lire en ligne, consulté le ).

- (en) R. Chamorro-Garcia, C. Diaz-Castillo, B. M. Shoucri et al., « Ancestral perinatal obesogen exposure results in a transgenerational thrifty phenotype in mice. », Nature Communications, vol. 8, no 1, (DOI 10.1038/s41467-017-01944-z., lire en ligne, consulté le ).

- (en) R. Stöger, « The thrifty epigenotype : an acquired and heritable predisposition for obesity and diabetes? », BioEssays, vol. 30, no 2, , p. 156–66 (PMID 18197594, DOI 10.1002/bies.20700).

- (en) C. N. Hales et David James Purslove Barker, « Type 2 (non-insulin-dependent) diabetes mellitus : the thrifty phenotype hypothesis », Diabetologia, vol. 35, no 7, , p. 595–601 (PMID 1644236, DOI 10.1007/BF00400248).

- C. Nicholas Hales et David James Purslove Barker, « The thrifty phenotype hypothesis : Type 2 diabetes », British medical bulletin, vol. 60, no 1, , p. 5–20 (PMID 11809615, DOI 10.1093/bmb/60.1.5, lire en ligne, consulté le ).

- Hélène Delisle, « La programmation fœtale des maladies chroniques liées à la nutrition », Cahiers d'études et de recherches francophones / Santé, vol. 12, no 1, (lire en ligne).

- (en) Chittaranjan S Yajnik, « Commentary : Thrifty phenotype: 20 years later », International Journal of Epidemiology, vol. 42, no 5, , p. 1227–1229 (DOI 10.1093/ije/dyt132, lire en ligne, consulté le ).

- (en) Jonathan C. K. Wells, « The Thrifty Phenotype Hypothesis : Thrifty Offspring or Thrifty Mother? », Journal of Theoretical Biology, Elsevier, vol. 221, no 1, , p. 143-161 (lire en ligne, consulté le ).
- (en) A. A. Vaag, L. G. Grunnet, G. P. Arora et al., « The thrifty phenotype hypothesis revisited », Diabetologia, vol. 55, no 8, , p. 2085–2088 (DOI 10.1007/s00125-012-2589-y, lire en ligne, consulté le ).

- (en) J. C. Wells, « The thrifty phenotype as an adaptive maternal effect. », Biological Reviews Cambridge Philosophical Society, Cambridge Philosophical Society, vol. 82, no 1, , p. 143-72 (lire en ligne, consulté le ).

- (en) Caitlin J Smith et Kelli K Ryckman, « Epigenetic and developmental influences on the risk of obesity, diabetes, and metabolic syndrome », Diabetes, Metabolic Syndrome and Obesity: Targets and Therapy, no 8, , p. 295–302 (DOI 10.2147/DMSO.S61296, lire en ligne, consulté le ).

- (en) Simon C. Langley-Evans, « Developmental programming of health and disease », Proc Nutr Soc., vol. 65, no 1, , p. 97–105 (lire en ligne, consulté le ).

- (en) C. E. Aiken et S. E. Ozanne, « Transgenerational developmental programming », Human Reproduction Update, vol. 20, , p. 63 (DOI 10.1093/humupd/dmt043, lire en ligne, consulté le ).

- Marie-Aline Charles, Cyrille Delpierre et Bernadette Bréant, « Le concept des origines développementales de la santé : Évolution sur trois décennies - Developmental origin of health and adult diseases (DOHaD): evolution of a concept over three decades », Med Sci (Paris), vol. 32, no 1 (dossier Origine développementale de la santé et des maladies (DOHaD), environnement et épigénétique), (lire en ligne, consulté le ).

- (en) J. C. Wells, « The thrifty phenotype as an adaptive maternal effect. », Biological Reviews Cambridge Philosophical Society, Cambridge Philosophical Society, vol. 82, no 1, , p. 143-72 (lire en ligne, consulté le ).
- (en) Caitlin J Smith et Kelli K Ryckman, « Epigenetic and developmental influences on the risk of obesity, diabetes, and metabolic syndrome », Diabetes, Metabolic Syndrome and Obesity: Targets and Therapy, no 8, , p. 295–302 (DOI 10.2147/DMSO.S61296, lire en ligne, consulté le ).
- (en) Simon C. Langley-Evans, « Developmental programming of health and disease », Proc Nutr Soc., vol. 65, no 1, , p. 97–105 (lire en ligne, consulté le ).

- (en) C. N. Hales et D. J. P. Barker, « Type 2 (Non-Insulin-Dependent) Diabetes Mellitus : The Thrifty Phenotype Hypothesis », International Journal of Epidemiology, vol. 42, no 5, , p. 1215-1222 (lire en ligne, consulté le ).
- C. Julien, « Obésité-diabète : génotype et/ou phénotype dʼépargne ? », Cholé-doc, Centre de recherche et d'information nutrionnelles, no 69, (lire en ligne, consulté le ).

- (en) Marie-Louise Barrenäs, Åsa Bratthall et Jovanna Dahlgren, « The thrifty phenotype hypothesis and hearing problems », The British Medical Journal, no 327, (DOI 10.1136/bmj.327.7425.1199, lire en ligne, consulté le ).

- (en) S. Ulisaszejk et E. Bryant, « Binge Eating, Dishinbition and Obesity », dans Alexandra Alvergne, Crispin Jenkinson et Charlotte Faurie (directeurs de publication), Evolutionary Thinking in Médicine : From Research to Policy and Practice, Springer, , 382 p. (lire en ligne), page 114.

- (en) Bonnie Brenseke, M. Renee Prater, Javiera Bahamonde et J. Claudio Gutierrez, « Current Thoughts on Maternal Nutrition and Fetal Programming of the Metabolic Syndrome », Journal of Pregnancy, , p. 1-13 (DOI 10.1155/2013/368461, lire en ligne, consulté le ).

- (en) Patrick Bateson, Behaviour, Development and Evolution, Open Book Publishers, , 134 p. (lire en ligne), page 91.

- (en) Patrick Bateson, Paul Patrick Gordon Bateson et Paul Martin, « Alternative Lifes », dans Patrick Bateson, Paul Patrick Gordon Bateson et Paul Martin, Design for a Life : How Biology and Psychology Shape Human Behavior, Simon and Schuster, , 271 p. (lire en ligne).

- (en) David Baker, « Fetal and Infant origins on Adult diseases », British Medical Journal, Londres, vol. 302, no 12, , p. 113 (lire en ligne [PDF], consulté le ).

- (en) R Huw Jones et Susan E Ozanne, « Fetal Programming of Glucose-Insulin Metabolism. », Molecular and Cellular Endocrinology, Elsevier, vol. 297, nos 1-2, (DOI 10.1016/j.mce.2008.06.020, lire en ligne [PDF], consulté le ).

- (en) Kara Calkins et Sherin U. Devaskar, « Fetal Origins of Adult Disease », Current Problems in Pediatric and Adolescent Health Care, Elsevier, vol. 41, no 6, , p. 158–176 (DOI 10.1016/j.cppeds.2011.01.001, lire en ligne, consulté le ).

Articles connexes
Liens externes
- (en) « Barker hypothesis », sur le site de l'Oxford University Press (consulté le ).
- Portail de la biologie
- Portail de la médecine